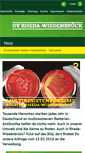

GRUENE-RHEDA-WIEDENBRUECK.DE
OV Rheda-Wiedenbrück: StartseiteDer Ortsverband Rheda-Wiedenbrück von BÜNDNIS 90/DIE GRÜNEN stellt sich vor.
http://www.gruene-rheda-wiedenbrueck.de/

Der Ortsverband Rheda-Wiedenbrück von BÜNDNIS 90/DIE GRÜNEN stellt sich vor.
http://www.gruene-rheda-wiedenbrueck.de/
TODAY'S RATING
>1,000,000
Date Range
HIGHEST TRAFFIC ON
Saturday

LOAD TIME
0.9 seconds
16x16
32x32
PAGES IN
THIS WEBSITE
0
SSL
EXTERNAL LINKS
2
SITE IP
91.102.13.20
LOAD TIME
0.92 sec
SCORE
6.2
OV Rheda-Wiedenbrück: Startseite | gruene-rheda-wiedenbrueck.de Reviews
https://gruene-rheda-wiedenbrueck.de
Der Ortsverband Rheda-Wiedenbrück von BÜNDNIS 90/DIE GRÜNEN stellt sich vor.
RHEDA-WIEDENBRÜCK » MEHR GRÜN FÜR DEN KREIS
http://gruene-kreisgt.de/die-ortsverbaende/rheda-wiedenbrueck
Seitenleiste mit weiterführenden Informationen. Der Suchbegriff nach dem die Website durchsucht werden soll. MEHR GRÜN FÜR DEN KREIS. Der Suchbegriff nach dem die Website durchsucht werden soll. Spenden Ohne Moos nichts los. Flüchtlinge & Asyl. Rang; Vor Ort. Lage Rheda-Wiedenbrück, Urheber TUBS. Es ist erlaubt, die Datei unter den Bedingungen der GNU-Lizenz für freie Dokumentation. Version 1.2 oder einer späteren Version, veröffentlicht von der. Homepage des Ortsverbands Rheda-Wiedenbrück. Wir wollen gu...
TOTAL LINKS TO THIS WEBSITE
2
![]() gruene-rendsburg-eckernfoerde.de
gruene-rendsburg-eckernfoerde.de
Home
Foto mit freundlichen Genehmigung von. P-La, Pressezentrum Langwedel. 092015 19:30 - 22:00. 092015 19:30 - 21:00. Herzlich willkommen auf den Seiten des Kreisverbandes Rendsburg-Eckernförde von BÜNDNIS 90/DIE GRÜNEN. Wir freuen uns über das Interesse und hoffen, dass wir Sie bzw. Dich für unsere Arbeit, unsere Ziele und unsere Visionen für einen sozialen, ökologischen und bürgernahen Kreis Rendsburg-Eckernförde begeistern können. Wir freuen uns auf Sie/Euch!
BÜNDNIS 90/DIE GRÜNEN Ortsverband Renningen
Mitglied werden / Spenden. BÜNDNIS 90/DIE GRÜNEN Renningen. Mobilitätskonzept Baden-Württemberg. Mittwoch 7.03.2018 20 Uhr. Die Studie Mobiles Baden-Württemberg- Wege der Transformation zu einer nachhaltigen Mobilität. Wurde initiiert und begleitet vom BUND Baden-Württemberg. Herzlichen Einladung an alle interessierten Bürgerinnen und Bürger. Thementreff: Bezahlbarer Wohnraum mehr! Grüner weihnachtlicher Treff mehr! Wir kämpfen für eine intakte Natur mit sauberem Wasser und einer innovativen Wirtschaft.
GRÜNE REUTLINGEN: HOME
DIE GRÜNEN IM KREIS REUTLINGEN. Mehr Grün vor Ort. Für uns im Bundestag: Beate Müller-Gemmeke. Für uns im Landtag: Thomas Poreski. Für uns im Europaparlament: Maria Heubuch. Grüne and Unabhängige Reutlingen. Grüne Bad Urach, Dettingen, vordere Alb. FÜR UNS IM LANDTAG UND IM BUNDESTAG. SIE SIND HIER: KV Reutlingen. Liebe Freundinnen und Freunde,. Liebe politisch interessierte Leserinnen und Leser,. Herzlich Willkommen auf der Homepage von Bündnis`90/DIE GRÜNEN im Kreis Reutlingen. Intergrationsturnier: Ki...
Grüne Rezepte für individuelle Gärten und Pflanzengesundheit - gruene-rezepte
Moderne, reduzierte Gärten. 6-812017 Münster: Treffen der Einzelunternehmer/innen. 1101-13.01.2017 Grünberg: Gehölzschnitt im öffentlichen und privaten Grün. 16-171.2017 Münster: Der Garten als vielfältiger Lebensraum. 191-21.1.2017 Grünberg: Pflege im Privatgarten Akquise, Planung und Abwicklung. 2501-27.01.2017 Grünberg: Gehölzschnitt im öffentlichen und privaten Grün. 3112017 Münster: Moderne Gartengestaltung und Erhaltung im Öko- und Biotrend. 12-222017 Münster: PraktikerIn im Pflegeservice. 191-21&#...
Grüner Kreisverband Rhein-Hunsrück: HOME
Bündnis 90/Die Grünen - Rheinland-Pfalz. Herzlich willkommen im Kreisverband Rhein-Hunsrück. BÜNDNIS 90 / DIE GRÜNEN. Sind im Landkreis Rhein-Hunsrück in den kommunalen Parlamenten der Verbandsgemeinden Kastellaun, Kirchberg und Simmern, den Städten Simmern und Boppard und dem Kreistag vertreten. Sie stehen dort für eine zukunftsorientierte, nachhaltige, ökologisch und sozial ausgerichtete Politik. Aktive Hilfe für Flüchtlinge im Rhein-Hunsrück-Kreis. Mitte Februar waren einige Mitglieder des grünen Krei...
OV Rheda-Wiedenbrück: Startseite
Die Grünen/ Bündnis 90 Rheda-Wiedenbrück auf Facebook. Wibke Brems: Unser Mitglied des Landtags NRW. Ratsinformationssystem der Stadt Rheda-Wiedenbrück. Sitzungskalender der Stadt Rheda-Wiedenbrück. Sonja von Zons (Rat). Thomas Birwe (Sachkundiger Bürger). Rainer Beckstett (Sachkundiger Bürger). Sitzverteilung im Rat und Wahlergebnisse. Klick auf das Bild, dort findest Du unsere Anfrage vom 15.02.2018 an die Verwaltung. Am 2510.2014 hat unsere Fraktion in einem Antrag eine Fahrradkonzept angeregt....
Grüne Rheiderland
Bündnis 90 / Die Grünen OV Rheiderland. Bündnis 90 / Die Grünen OV Rheiderland. Du bist hier: Bündnis 90 / Die Grünen OV Rheiderland. Neuer Vorstand im OV Rheiderland. Der neu gewählte Vorstand der Rheiderländer GRÜNEN. Einstimmig votierten die Mitglieder am 26.03. für Friedrich Bruns, re. und Friedhorst Friedl. PM: Baugebiet hinter Edeka ist der falsche Weg. Abgelegt unter: Pressemitteilungen Fraktion Weener. Hessepark zukünftige Entwicklung und Attraktivitätssteigerung, Antrag im Bau- und Umweltausschuß.
GRÜNE REK: Grüne im Rhein-Erft-Kreis
Harald Dieter Schmidt-El Khaldi. Wir sind aktiv bilder. Kein Ei mit der 3. Menschenkette 12.3.011. Anti AKW Demo Berlin. Mit Dir Wirds Was! Harald Dieter Schmidt-El Khaldi. Wirtschaft-Verkehr, Pressemitteilung-Fraktion 22.03.2018. REVG wird operativer Verkehrsdienstleister. Der Kreistag des Rhein-Erft-Kreises machte in seiner Sitzung am 15.03.2018 den Weg frei für die. Pressemitteilung-Fraktion, Verwaltung 07.03.2018. Jamaika Koalition will deutliche Entlastung der Kommunen auch im laufenden Jahr.
Start - Die Grünen KTF Neuss
Unsere Geschäftsstelle in der Neusser Innenstadt. So finden Sie uns. Zu den Büroöffnungszeiten der Kreistagsfraktion. Zu den Büroöffnungszeiten des Kreisverbandes. Suche in http:/ gruene-rhein-kreis-neuss.de/. Letzte Aktualisierung: 02.08.2015. Des Kreisverbands finden Sie hier. Sonntag, 13. September - einen neuen Landrat für den Rhein-Kreis Neuss wählen. Klick - ext. Link zur Website. Sonntag, 13. September - eine neue BürgermeisterIn für Neuss wählen! Klick - ext. Link zu gruene-neuss.de. KTF: Resolut...
Grüne Rhein-Neckar-Kreis
Grüne Kreisverbände im Rhein-Neckar-Kreis. Der Rhein-Neckar-Kreis ist bei Bündnis 90/Die Grünen untergliedert in drei Kreisverbände (KV):. Zudem gibt es in der Region die beiden städtischen Kreisverbände. Termine, Kontakt-Daten und weitere Informationen zu den Kreis- und Ortsverbänden finden sie – durch Anklicken des Namens – auf der Homepage des jeweiligen KV.
Kreisverband Rhein-Pfalz
Seitenleiste mit weiterführenden Informationen. Links zu GRÜNEN Webseiten:. Der Suchbegriff nach dem die Website durchsucht werden soll. Der Suchbegriff nach dem die Website durchsucht werden soll. 404 — Not Found. It seems that the page you were trying to reach does not exist anymore, or maybe it has just moved. You can start again from the home. Or go back to previous page. Elias Weinacht auf Platz 20 der Landesliste gewählt. 22 Juni 2015, um 00:51 Uhr. 28 Mai 2015, um 17:30 Uhr. Man muss nicht Pendler...
SOCIAL ENGAGEMENT